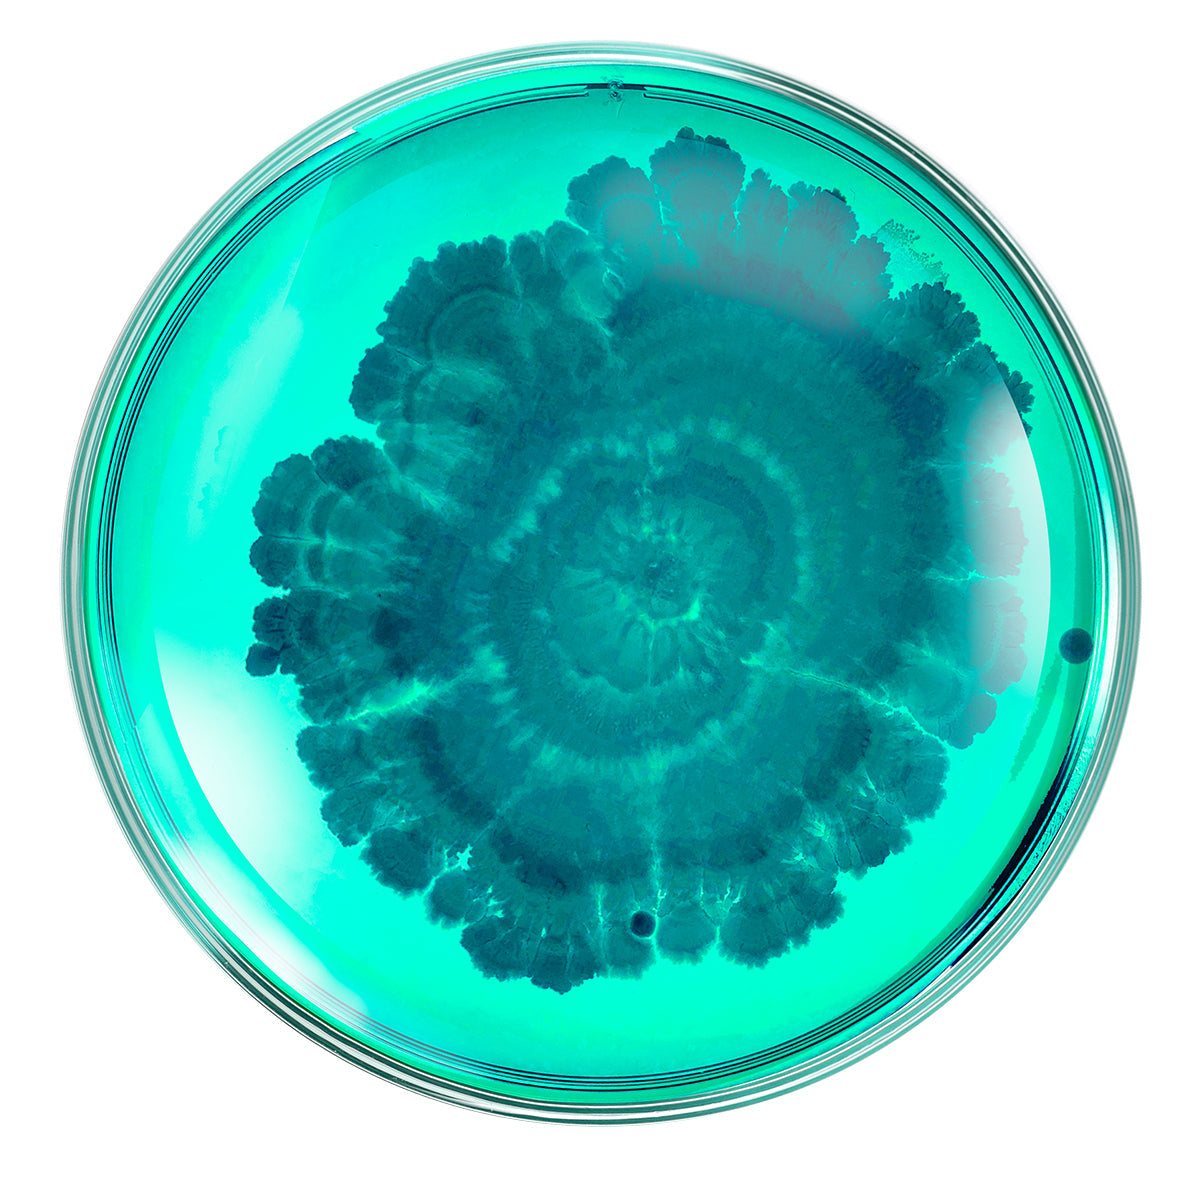

ausgewählte Naturkosmetik für ein strahlendes Hautbild
Zügiger Versand - gratis Produktproben
ab 69 Euro versandkostenfrei
We use cookies and similar technologies to provide the best experience on our website.

ROQ Cosmetics
Probiotika und das Mikrobiom der Haut – Warum sie für deine Hautgesundheit so wichtig sind

Das Hautmikrobiom – Dein unsichtbarer Schutzmantel für gesunde, strahlende Haut

Die perfekte Hautpflegeroutine – Dein tägliches Ritual für gesunde, strahlende Haut


- ROQ Cosmetics
Return of Quality
Naturkosmetik, bio-zertifizierte Kosmetik, Premium MakeUp und Clean Beauty!
Für uns, unsere Haut und unsere Umwelt. Alle Produkte und Marken sind handverlesen und mit viel Liebe ausgewählt.
Natürlich verzichten wir auf unschöne Inhaltsstoffe und genießen dafür umso mehr wundervolle Premium Kosmetik ohne auf Wirkung verzichten zu müssen. Jede Haut ist anders und die Bedürfnisse sind sehr unterschiedlich.
ÜBER UNS

Naturkosmetik, bio-zertifizierte Kosmetik, Premium MakeUp und Clean Beauty!